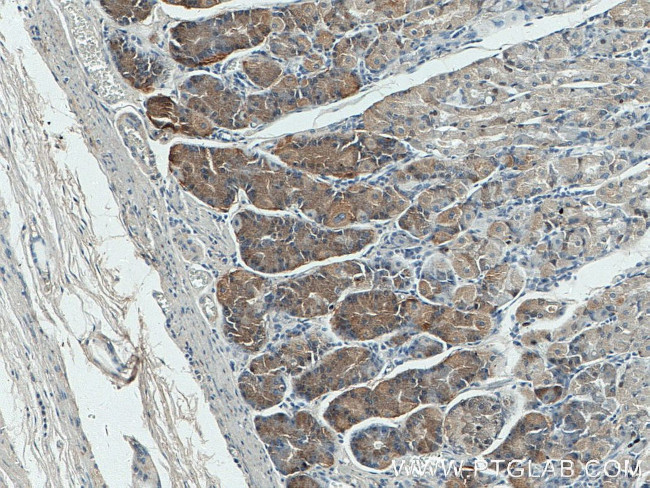
Beclin 1 Antibody in Immunohistochemistry (Paraffin) (IHC (P))

Search
Proteintech
Beclin 1 Monoclonal Antibody (1C10C4)
{{$productOrderCtrl.translations['antibody.pdp.commerceCard.promotion.promotions']}}
{{$productOrderCtrl.translations['antibody.pdp.commerceCard.promotion.viewpromo']}}
{{$productOrderCtrl.translations['antibody.pdp.commerceCard.promotion.promocode']}}: {{promo.promoCode}} {{promo.promoTitle}} {{promo.promoDescription}}. {{$productOrderCtrl.translations['antibody.pdp.commerceCard.promotion.learnmore']}}
产品信息
66665-1-IG
种属反应
已发表种属
宿主/亚型
分类
类型
克隆号
抗原
偶联物
形式
浓度
纯化类型
保存液
内含物
保存条件
运输条件
产品详细信息
Immunogen sequence: TDTLLDQLD TQLNVTENEC QNYKRCLEIL EQMNEDDSEQ LQMELKELAL EEERLIQELE DVEKNRKIVA ENLEKVQAEA ERLDQEEAQY QREYSEFKRQ QLELDDELKS VENQMRYAQT QLDKLKKTNV FNATFHIWHS GQFGTINNFR LGRLPSVPVE WNEINAAWGQ TVLLLHALAN KMGLKFQRYR LVPYGNHSYL ESLTDKSKEL PLYCSGGLRF FWDNKFDHAM VAFLDCVQQF KEEVEKGETR FCLPYRMDVE KGKIEDTGGS GGSYSIKTQF NSEEQWTKAL KFMLTNLKWG LAWVSSQFYN K (141-450 aa encoded by BC010276)
靶标信息
Beclin 1 plays a central role in autophagy. It acts as a core subunit of the PI3K complex that mediates formation of phosphatidylinositol 3-phosphate. Different PI3K complex forms are believed to play a role in multiple membrane trafficking pathways - PI3KC3-C1 is involved in the initation of autophagosomes and PI3KC3-C2 is involved in the maturation of autophagosomes and endocytosis. Beclin 1 also plays a role in antiviral host defense.
仅用于科研。不用于诊断过程。未经明确授权不得转售。
生物信息学
蛋白别名: APG6; ATG6 autophagy related 6 homolog; Bcl-2-interacting protein beclin; beclin 1 (coiled-coil, moesin-like BCL2-interacting protein); beclin 1 (coiled-coil, myosin-like BCL2-interacting protein); beclin 1, autophagy related; Beclin-1; Coiled-coil myosin-like BCL2-interacting protein; coiled-coil, myosin-like BCL2-interacting protein; Protein GT197; testis secretory sperm-binding protein Li 215e
基因别名: 4921513J16Rik; 5430417M23Rik; ATG6; beclin1; BECN1; GT197; VPS30
UniProt ID: (Human) Q14457, (Rat) Q91XJ1, (Mouse) O88597
Entrez Gene ID: (Human) 8678, (Rat) 114558, (Mouse) 56208